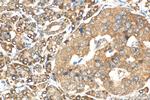
PSF2 Antibody in Immunohistochemistry (Paraffin) (IHC (P))

Search
Proteintech
PSF2 Polyclonal Antibody
{{$productOrderCtrl.translations['antibody.pdp.commerceCard.promotion.promotions']}}
{{$productOrderCtrl.translations['antibody.pdp.commerceCard.promotion.viewpromo']}}
{{$productOrderCtrl.translations['antibody.pdp.commerceCard.promotion.promocode']}}: {{promo.promoCode}} {{promo.promoTitle}} {{promo.promoDescription}}. {{$productOrderCtrl.translations['antibody.pdp.commerceCard.promotion.learnmore']}}
产品信息
16247-1-AP
种属反应
已发表种属
宿主/亚型
分类
类型
抗原
偶联物
形式
浓度
规格
纯化类型
保存液
内含物
保存条件
运输条件
产品详细信息
Immunogen sequence: MDAAEVEFL AEKELVTIIP NFSLDKIYLI GGDLGPFNPG LPVEVPLWLA INLKQRQKCR LLPPEWMDVE KLEKMRDHER KEETFTPMPS PYYMELTKLL LNHASDNIPK ADEIRTLVKD MWDTRIAKLR VSADSFVRQQ EAHAKLDNLT LMEINTSGTF LTQALNHMYK LRTNLQPLES TQSQDF (1-185 aa encoded by B C010164)
靶标信息
The yeast heterotetrameric GINS complex is made up of Sld5, Psf1, Psf2, and Psf3. The formation of this complex is essential for the initiation of DNA replication in yeast and Xenopus egg extracts (Ueno et al., 2005 ). See GINS1 for additional information about the GINS complex.
仅用于科研。不用于诊断过程。未经明确授权不得转售。
生物信息学
蛋白别名: DNA replication complex GINS protein PSF2; GINS complex subunit 2; GINS complex subunit 2 (Psf2 homolog); Pfs2; unnamed protein product
基因别名: 2210013I18Rik; 4833427B12Rik; AI323585; CGI-122; DC5; GINS2; HSPC037; Pfs2; PSF2; RGD1311055
UniProt ID: (Human) Q9Y248, (Mouse) Q9D600
Entrez Gene ID: (Human) 51659, (Mouse) 272551, (Rat) 292058